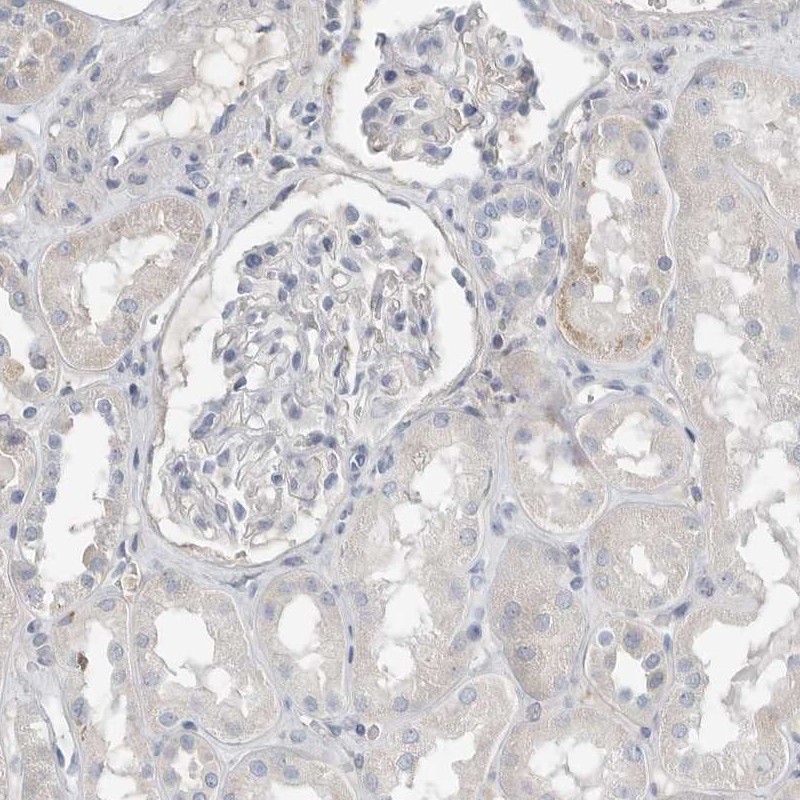

All products are designed for the highest possible performance and are manufactured using a standardized process to ensure the most rigorous levels of quality.
The Anti‑SERPINB7 antibody (HPA024200) enables precise detection of SERPINB7, a disease‑related intracellular protein with strong expression in skin and lymphoid tissues, according to the Human Protein Atlas. SERPINB7 belongs to the serpin family and is associated with skin keratinization, clustering within the “Skin – Keratinization (mainly)” RNA expression group.
Significance in Research: HPA profiling shows cytoplasmic and nuclear expression in subsets of keratinocytes in both skin and tonsil, with subcellular localization predominantly in the endoplasmic reticulum and additionally in the mitochondria. This antibody is well suited for studies of epithelial biology, keratinocyte differentiation, skin barrier function, and SERPIN‑linked disease mechanisms, making it an excellent tool for dermatology, immunology, and pathology research.
Corresponding antigens
With Atlas Antibodies you get

From our facilities in Stockholm, Sweden we develop, manufacture and distribute highly advanced reagents to the Life Sciences community worldwide.

Our products are available to customers worldwide. From most locations, you can order our products from Atlas Antibodies. Please see more information about how to order here.

Learn how we validate our antibodies, how we secure their reproducibility, and why we apply enhanced validation. Our antibodies are validated in IHC, ICC-IF, and WB.